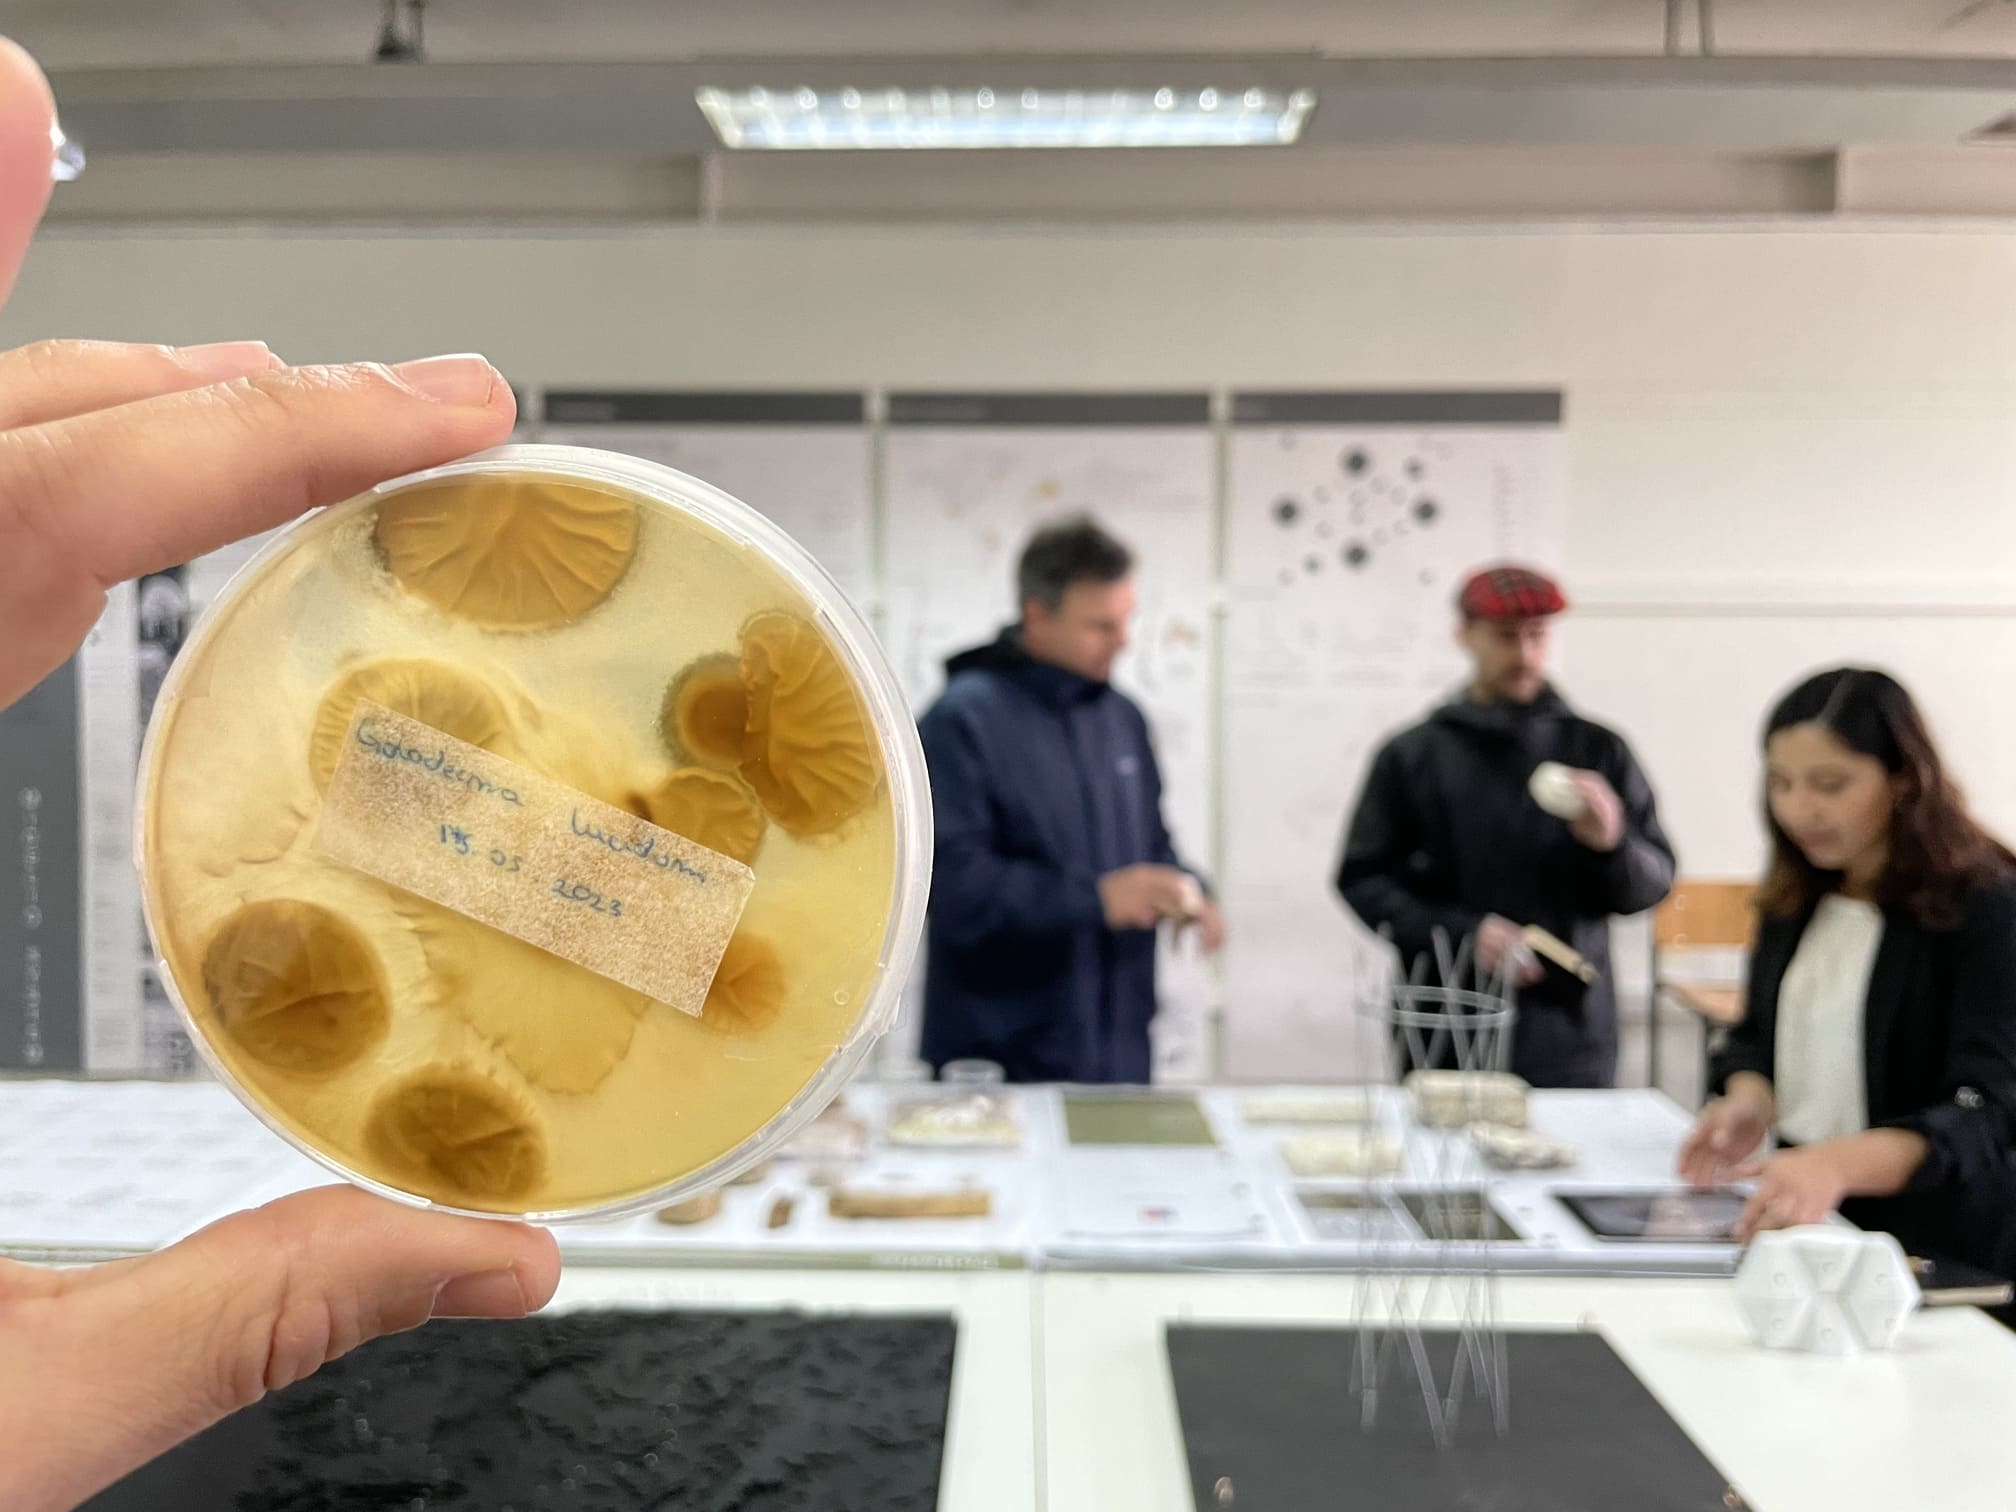

Compartir

Directora: Elizabeth Wagemann
Desde 2012, el Laboratorio Ciudad y Territorio genera conocimiento sobre fenómenos urbanos en relación con territorio, naturaleza y sociedad. De carácter colaborativo y multidisciplinar, conecta a estudiantes de pre y posgrado con la investigación y fomenta vínculos con instituciones públicas y privadas. Su trabajo se organiza en tres líneas: Territorio y entorno, Vivienda y sociedad, y Movilidad y forma urbana, valorando procesos innovadores y metodologías aplicadas.











El Laboratorio de Creación Artística promueve programas que involucran la generación y transferencia de conocimiento a partir de prácticas artísticas, metodologías experimentales y especulativas. Posee un carácter inter y transdisciplinar de trabajo colaborativo, que involucra programas específicos (Programa de Investigación y Creación Gráfica; Programa de Pensamiento Transdisciplinar; Programa de Creación Artística para docentes) con la comunidad UDP e instituciones externas, valorando procesos y metodologías singulares.











El Laboratorio de Innovación y Creación (LINC) de la FaAAD es un espacio que promueve la investigación aplicada y la docencia como motores para proyectar el diseño hacia la industria, la tecnología y la sociedad. Su propósito es potenciar a estudiantes y egresados en la transformación de sus proyectos académicos en oportunidades de emprendimiento e innovación con impacto real. Desde la gestión, el LINC acompaña en la formulación y postulación de fondos, provee un marco metodológico para el desarrollo de proyectos y genera un network de conocimientos con agentes internos y externos. Estos factores permiten posicionar e impulsar las propuestas hacia el entorno, aportando al desarrollo productivo, cultural y social.











El Laboratorio de Materiales y Prototipos promueve la investigación aplicada en diseño y materialización, potenciando el intercambio entre academia, sociedad e industria. De carácter colaborativo e interdisciplinar, impulsa iniciativas en investigación, innovación y vinculación con el medio. Sus líneas son: diseño y fabricación avanzada, innovación constructiva-estructural, sistemas materiales y energía e impacto ambiental. Integra la formación académica y fomenta la interacción cultural mediante proyectos, talleres y actividades con la comunidad.